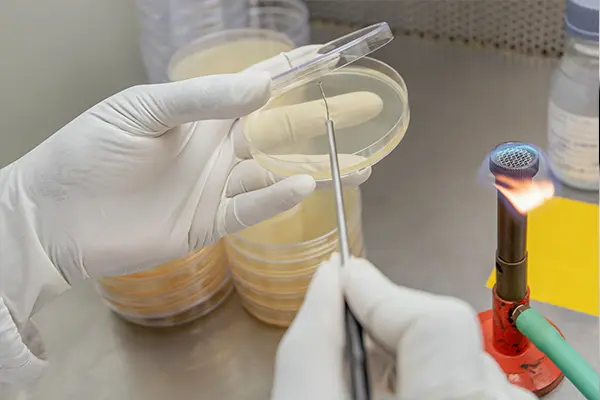
R&D

Research & Development
Bioplus Life Sciences is a research-driven company, continually evolving and aspires to improve products and service quality through the utilization of the latest technology combined with extensive research and experimentation on food ingredients and Nutraceutical products.
Read More